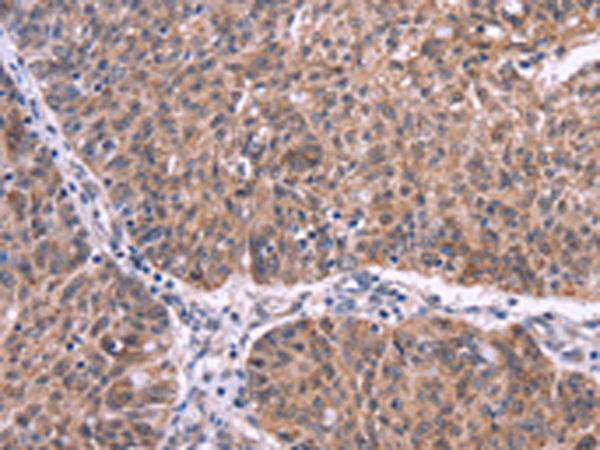
一抗

|
Background: |
Ephrin-A5, a member of the ephrin gene family, prevents axon bundling in cocultures of cortical neurons with astrocytes, a model of late stage nervous system development and differentiation. The EPH and EPH-related receptors comprise the largest subfamily of receptor protein-tyrosine kinases and have been implicated in mediating developmental events, particularly in the nervous system. EPH receptors typically have a single kinase domain and an extracellular region containing a Cys-rich domain and 2 fibronectin type III repeats. The ephrin ligands and receptors have been named by the Eph Nomenclature Committee (1997). |
|
Applications: |
ELISA, IHC |
|
Name of antibody: |
EFNA5 |
|
Immunogen: |
Synthetic peptide of human EFNA5 |
|
Full name: |
ephrin-A5 |
|
Synonyms: |
AF1; EFL5; RAGS; EPLG7; GLC1M; LERK7 |
|
SwissProt: |
P52803 |
|
ELISA Recommended dilution: |
2000-5000 |
|
IHC positive control: |
Human ovarian cancer and Human colon cancer |
|
IHC Recommend dilution: |
50-200 |

 購物車
購物車 幫助
幫助
 021-54845833/15800441009
021-54845833/15800441009